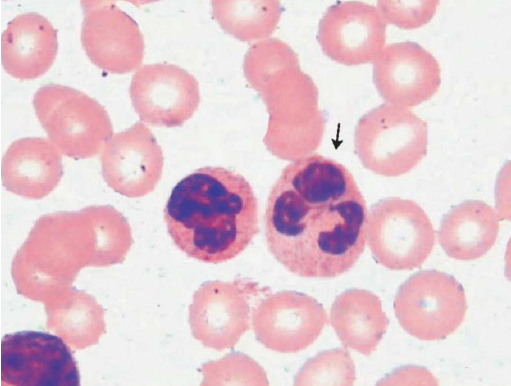
17615449239980271694.png

高频考题
1、血清中缺少的物质是
A、某些凝血因子B、碱性蛋白质
C、网织红细胞
D、吞噬细胞
E、淋巴细胞
【答案】A
【解析】血清中缺少的是某些凝血因子,如凝血因子Ⅰ(纤维蛋白原)、Ⅱ(凝血酶原)、Ⅴ、Ⅷ等。
2、钠、钾、氯离子的主要排泄器官是
A、皮肤B、肠道
C、肝脏
D、肾脏
E、肺
【答案】D
【解析】肾脏是人体重要的排泄器官,主要生理功能是排泄体内多余的水分和代谢产物,并调节水、电解质和酸碱平衡,这对维持生命系统的稳态至关重要。
3、人类B淋巴细胞发育成熟的部位是
A、骨髓B、法氏囊
C、胸腺
D、脾脏
E、扁桃体
【答案】A
【解析】B淋巴细胞是在骨髓内发育成熟的细胞,又称为骨髓依赖性淋巴细胞,是免疫系统中的一种主要细胞。
4、可引起Ⅰ型超敏反应的抗原为
A、油漆B、变性IgG
C、花粉
D、血型抗原
E、核抗原
【答案】C
【解析】可引起Ⅰ型超敏反应的抗原是C:花粉。
变应原可引起Ⅰ型超敏反应,其中吸入性变应原包括花粉颗粒、尘螨排泄物、真菌丝及孢子、昆虫毒液、动物皮毛等。
5、关于RDW的全称,正确的是
A、平均红细胞容积B、平均红细胞血红蛋白浓度
C、平均白细胞血红蛋白浓度
D、红细胞体积分布宽度
E、网织红细胞体积分布宽度
【答案】D
【解析】红细胞体积分布宽度(RDW)是衡量样本中红细胞体积大小异质性的指标,它通过血液分析仪的红细胞体积直方图计算得出。
这一参数有助于评估红细胞的大小变异程度,相比于直接观察血涂片上的红细胞形态,RDW提供了一种更客观、精确的评价方式。
6、患者,女,25岁。因尿频、尿急、尿痛3天就诊。体检:体温40°C,右肾区有叩痛,实验室检查:尿液外观浑浊,尿蛋白(++),尿白细胞布满视野,红细胞7~12个/HP,最可能的诊断是
A、急性尿道炎B、急性膀胱炎
C、急性肾盂肾炎
D、肾结石
E、急性肾小球肾炎
【答案】C
【解析】患者出现的症状包括高热、尿频、尿急、尿痛,以及尿液浑浊、蛋白尿、尿中大量白细胞和红细胞,这些临床表现高度提示急性肾盂肾炎的可能性。
急性肾盂肾炎通常由细菌感染引起,其特征包括尿路刺激征(如尿频、尿急、尿痛)、发热、白细胞尿(尿中白细胞数量显著增加)和脓尿(尿中可见白细胞管型)。
因此,结合患者的临床表现和实验室检查结果,正确的诊断应为急性肾盂肾炎。
7、临床常用标记抗体检测相应抗原,是由于抗原抗体反应具有
A、特异性B、比例性
C、可逆性
D、亲和性
E、带现象
【答案】A
【解析】抗原与抗体结合高度的特异性,是应用于临床诊断的基础。因此,正确答案是 A:特异性。
8、甲状旁腺激素升高导致
A、钙升高,磷降低B、钙升高,磷升高
C、钙降低,磷升高
D、钙降低,磷降低
E、钙磷不变
【答案】A
【解析】甲状旁腺激素主要作用是提升血钙水平并降低血磷水平。
因此,当甲状旁腺激素升高时,会导致血钙升高而血磷降低。
故正确答案为:A:钙升高,磷降低。
9、检测抗原时,抗原抗体反应的最佳条件不包括
A、抗原抗体比例在合适范围B、8.5g/L盐水或其他缓冲液
C、反应溶液pH6~8
D、反应温度56℃
E、有高度特异性、高亲和力抗体
【答案】D
【解析】检测抗原时,理想的抗原抗体反应条件包括合适的抗原抗体比例、使用8.5g/L盐水或其他缓冲液作为反应溶液、保持pH值在6-8之间以及使用具有高度特异性与高亲和力的抗体。
反应温度通常应维持在15-40℃的范围内,常用的是37℃。
因此,错误的选项是D:反应温度56℃,因为高温(如56℃)可能会导致已结合的抗原抗体复合物重新解离,甚至导致抗原或抗体的变性或破坏。
10、属于酮体的三种物质是
A、丙酮、β-羟丁酸、乙酰乙酸B、丙酮、丙酮酸、β-羟丁酸
C、乙酰CoA、β-羟丁酸、乙酰乙酸
D、乙酰CoA、丙酮、乙酰乙酸
E、乙酰乙酸、丙酮酸、β-羟丁酸
【答案】A
【解析】答案是A:丙酮、β-羟丁酸、乙酰乙酸。
尿酮体是尿液中乙酰乙酸(占20%)、β-羟丁酸(占78%)及丙酮(占2%)的总称。
11、下列HLA座位中,对器官移植排斥反应影响最大的是
A、HLA-AB、HLA-B
C、HLA-C
D、HLA-DR
E、HLA-E
【答案】D
【解析】在三类HLA分子中,Ⅰ、Ⅱ类分子是触发移植排斥反应的首要抗原,尤其是HLA-DR位点的抗原分子。
12、不能经糖异生途径合成葡萄糖的物质是
A、α-磷酸甘油B、丙酮酸
C、乳酸
D、乙酰CoA
E、生糖氨基酸
【答案】D
【解析】糖异生作用:在较长时间饥饿后,氨基酸、甘油等非糖物质在肝内经糖异生作用生成葡萄糖,而乙酰CoA是酶具有催化作用不能经过糖异生途径可合成葡萄糖,是由葡萄糖代谢生成的。
13、血琼脂平板属于
A、基础培养基B、鉴别培养基
C、选择培养基
D、营养培养基
E、特殊培养基
【答案】D
【解析】血琼脂平板、巧克力血平板,含有细菌生长所需要的生长因子及微量元素,属于营养培养基。糖发酵管、伊红-亚甲蓝琼脂属于鉴别培养基。SS琼脂属于选择培养基。疱肉培养基、巯基乙醇酸钠培养基属于特殊培养基。因此,正确答案是选项D:营养培养基。
14、正常血清中,补体含量最高的是
A、C1B、C2
C、C3
D、C4
E、C9
【答案】C
【解析】正常血清中,补体含量最高的成分是C3。
15、下列哪种链球菌呈矛头状,成双排列,有时呈短链状排列
A、肺炎链球菌B、化脓性链球菌
C、无乳链球菌
D、草绿色链球菌
E、丙型链球菌
【答案】A
【解析】肺炎链球菌:革兰氏阳性球菌。呈矛尖状,钝面成双排列,有时呈短链状,直径0.5~1.25μm,有荚膜(在人或动物体内易形成),无鞭毛,无芽孢。这些特点帮助其区别于其他选项中的链球菌类型。
16、网织红细胞活体染色的物质为
A、亚甲蓝B、淡绿
C、新亚甲蓝
D、俾士麦棕
E、伊红
【答案】C
【解析】网织红细胞活体染色所使用的物质是新亚甲蓝。
经体外活体染色,网织红细胞内RNA的磷酸基带有负电荷,能与新亚甲蓝、煌焦油蓝、中性红等碱性染料带正电荷的有色反应基团结合。
17、具有免疫记忆功能的细胞是
A、NK细胞B、巨噬细胞
C、T细胞
D、中性粒细胞
E、嗜碱粒细胞
【答案】C
【解析】具有免疫记忆功能的细胞是T细胞。
当T细胞或B细胞再次遇到相同的抗原时,它们可以迅速活化、增殖并分化为执行高效而持久的特异性免疫效应功能的细胞。
这一过程使得机体能够对先前接触过的病原体产生更快、更强的免疫反应。
18、患者男,45岁。7月从缅甸工作回来后出现高热、寒战,体温高达40℃以上。血涂片检查如图所示,该患者最可能的诊断是
A、弓形虫
B、疟原虫
C、丝虫
D、杜氏利什曼原虫
E、回归热螺旋体
【答案】B
【解析】疟原虫早期滋养体形态:早期滋养体(环状体)胞质少,中间有空泡,胞质被挤向周边呈环状,核位于一侧,形似指环。题中图与该描述相似。疟疾主要流行于热带和亚热带,其次为温带。该患者7月从缅甸工作回来后出现高热、寒战。故考虑是疟原虫。
19、患儿男,8岁。上学时不慎摔倒,膝部出现水肿。既往有类似情况发生。父母身体健康。
A、内源性凝血系统缺陷B、外源性凝血系统缺陷
C、共同凝血系统缺陷
D、血管壁缺陷
E、病理性抗凝物质增加
【答案】A
【解析】本题答案选A:内源性凝血系统缺陷。
解析:根据题目描述的患儿症状以及既往经历,怀疑其可能患有血友病。
血友病是一组遗传性因子VIII和IX基因缺陷、基因突变、基因缺失、基因插入等导致内源凝血途径激活凝血酶原酶的功能发生障碍所引起的出血性疾病
20、基因分节段的呼吸道病毒是
A、流感病毒B、麻疹病毒
C、腮腺炎病毒
D、呼吸道合胞病毒
E、腺病毒
【答案】A
【解析】流感病毒的遗传物质是单股负链RNA,甲型和乙型流感病毒的RNA由8个节段组成,丙型流感病毒则比他们少一个节段。
21、蛋白尿是指尿液中的蛋白质含量为
A、100mg/24hB、150mg/24h
C、200mg/24h
D、250mg/24h
E、500mg/24h
【答案】B
【解析】当尿液中蛋白质超过150mg/24h或超过100mg/L时,蛋白定性试验呈阳性,即称为蛋白尿。因此,正确的选项是B:150mg/24小时。
22、患者女,40岁。近来出现体重增加及向心性肥胖,四肢肌肉萎缩,腹部有紫斑,多毛。实验室检查:血糖增高,葡萄糖耐量减低,血红细胞增高,白细胞总数及中性粒细胞增高,血Na+增高,K+、Ca2+降低,临床诊断可考虑
A、嗜络细胞瘤B、Addis病
C、肾上腺皮质功能亢进
D、甲状腺功能亢进
E、泌乳素瘤
【答案】C
【解析】患者表现包括体重增加、向心性肥胖、四肢肌肉萎缩、腹部紫斑以及多毛等症状,结合实验室检查结果如血糖增高、葡萄糖耐量减低、血红细胞增高、白细胞总数及中性粒细胞增高、血Na+增高、K+、Ca2+降低等,这些特征指向了肾上腺皮质功能亢进这一诊断。
具体而言,过量的皮质醇(一种由肾上腺皮质分泌的激素)会导致上述代谢异常和临床表现。
因此,正确的选项是C:肾上腺皮质功能亢进。
23、甲状腺合成T3、T4的过程中摄取和活化的元素是
A、钙B、磷
C、镁
D、碘
E、铁
【答案】D
【解析】甲状腺合成T3、T4的过程中摄取和活化的关键元素是碘(选项D)。
24、属于细菌基本结构的是
A、菌毛B、芽孢
C、荚膜
D、鞭毛
E、核质
【答案】E
【解析】核质是细菌的基本结构之一,由一条闭环双链DNA组成,是细菌的主要遗传物质,决定细菌的性状和遗传特征。
25、患者女,40岁。反复黄疸,乏力3年,加重3个月。WBC8.7×109/L,RBC1.04×1012/L,Hb42g/L,PLT95×109/L,外周血看见幼红细胞及晚幼粒细胞,并可见红细胞形态异常。Coombs(+),下列最有可能的诊断是
A、缺铁性贫血B、地中海贫血
C、遗传性球形红细胞增多症
D、G-6-PD缺乏症
E、自身免疫溶血性贫血
【答案】E
【解析】抗人球蛋白试验(Coombs试验):检测自身免疫性溶血性贫血的自身抗体(IgG)。故选E。其他选项不符合上述临床特征和实验室结果。
26、某医院化验室前放置一个存放化验单的箱子,任何人打开即可查看所有病人的化验结果。为方便查找,不同病理结果箱有不同标识,如“大小便、胸腹水、前列腺常规、白带常规、防癌普查”等。医院的做法不符合医德规范的要求。
A、救死扶伤,实行社会主义的人道主义B、尊重病人的人格
C、文明礼貌服务
D、为病人保守秘密,实行保护性医疗
E、严谨求实
【答案】D
【解析】医院将所有病人的化验结果公开放置,违背了为病人保守秘密、实行保护性医疗的基本医德规范。
这一做法侵犯了患者的隐私权,不符合尊重病人人格和实施保护性医疗的原则。
因此,正确答案是D:为病人保守秘密,实行保护性医疗。
27、急性白血病诊断的主要依据是
A、发热、贫血、出血B、白细胞计数>50×109/L
C、骨髓增生极度活跃
D、胸骨压痛(+)
E、骨髓中原始细胞明显增高
【答案】E
【解析】急性白血病的主要依据是骨髓中原始细胞(或原始加幼稚细胞)的明显增高,超过30%。
这是因为在急性白血病中,造血前体细胞在早期阶段分化、发育受阻,导致骨髓和外周血中该系列的原始细胞比例显著增加。
这一特征性改变有助于急性白血病的诊断。
28、某患者,男,45岁。无“三多一少”症状,空腹血糖7.2mmol/L;OGTT:空腹6.9mmol/L,餐后2小时11.8mmol/L,可诊断为
A、糖尿病B、需再做一次OGTT
C、空腹血糖受损
D、糖耐量异常
E、无法诊断
【答案】A
【解析】对于题目中的描述,患者无糖尿病典型症状,但其空腹血糖水平为7.2 mmol/L,餐后2小时血糖水平为11.8 mmol/L。
这些数值超过了糖尿病的诊断标准:
- 空腹血糖 ≥ 7.0 mmol/L
- 餐后2小时血糖 ≥ 11.1 mmol/L
因此,根据所提供的信息,正确的答案是 A:糖尿病。
这表明患者符合糖尿病的诊断标准。
29、正常人红细胞的平均寿命约为
A、60天B、80天
C、100天
D、120天
E、160天
【答案】D
【解析】正常人红细胞的平均寿命约为120天。
网织红细胞经约48h成为完全成熟的红细胞,释放入血液。红细胞平均寿命约120d,衰老红细胞主要在脾破坏,分解为铁、珠蛋白和胆红素。
30、血小板的止血功能不包括
A、聚集功能B、促凝功能
C、血液凝固功能
D、黏附功能
E、释放功能
【答案】C
【解析】血小板的止血功能主要包括:
1. 黏附功能:血小板黏着于血管内皮下组分或其他异物表面。
2. 聚集功能:血小板与血小板之间的相互黏附形成血小板团。
3. 释放功能:血小板在诱导剂作用下,释放其内部的活性物质。
4. 促凝功能:涉及多种机制促进血液凝固,包括PF3的促凝活性、接触产物生成活性、胶原诱导的凝血活性以及α颗粒中凝血因子的释放。
5. 血块收缩功能:血小板使血凝块收缩,有助于伤口愈合。
6. 维护血管内皮完整性:血小板充填受损血管内皮细胞脱落形成的空隙,参与血管内皮细胞的再生和修复。
因此,本题的正确答案为C: 血液凝固功能,并非血小板的直接止血功能之一。
31、下列各项血脂指标中,生理性变异最大的是
A、TCB、TG
C、HDL-C
D、ApoAⅠ
E、ApoB100
【答案】B
【解析】生理性变异最大的血脂指标是TG(甘油三酯)。
TG水平受生活习惯、饮食条件、年龄、性别等因素影响较大,因此在个体内和个体间的差异较其他血脂指标(如总胆固醇TC、高密度脂蛋白胆固醇HDL-C、载脂蛋白AⅠApoAⅠ、载脂蛋白B100ApoB100)更为显著。
32、患者,女,28岁。反复发作性腹痛、腹泻2年,发作时每天大便5~6次,有黏液,间歇期有时便秘,伴全身乏力、失眠。查体:轻度贫血貌,左下腹可扪及条索状物。大便镜检:红细胞2~5/HP,白细胞20~25/HP。下列诊断最可能的是
A、急性菌痢B、慢性菌痢
C、直肠癌
D、肠结核
E、结肠癌
【答案】B
【解析】患者表现反复发作性腹痛、腹泻,持续2年,大便检查发现红细胞和白细胞异常,这符合慢性菌痢的症状。
慢性菌痢是由于细菌性痢疾反复发作导致的结肠炎症,常表现为慢性腹泻、腹痛和粘液便。
其他选项与患者症状不符或病症不同:
- A项“急性菌痢”通常表现为起病急,症状严重,不同于患者描述的慢性过程。
- C项“直肠癌”通常伴有不同性质的便血、排便习惯改变、体重下降等症状,与患者情况不完全匹配。
- D项“肠结核”多见于肺结核患者的肠道表现,症状和大便检查结果可能有特定特点,但患者描述信息不足以确定为肠结核。
- E项“结肠癌”同样可能伴随类似症状,但通常会更严重,且伴随其他特异性症状,需要进一步的检查以明确诊断。
综上所述,根据患者病史和大便检查结果,最可能的诊断是B项“慢性菌痢”。
33、氰化高铁血红蛋白测定血红蛋白的吸收波峰为
A、538nmB、540nm
C、542nm
D、575nm
E、582nm
【答案】B
【解析】氰化高铁血红蛋白测定血红蛋白的吸收波长为540nm。
氰化高铁血红蛋白,其在540nm处有一吸收峰,用分光光度计测定该处的吸光度,经换算即可得到每升血液中的血红蛋白浓度。
34、妊娠时,尿中HCG含量出现高峰的时间约在
A、4~6周B、8~10周
C、11~13周
D、14~16周
E、分娩时
【答案】B
【解析】妊娠时,尿中HCG(人绒毛膜促性腺激素)含量出现高峰的时间约为8~10周。
这是因为在受精卵着床后,hCG的分泌量迅速增加,在妊娠早期达到高峰,并在8~10周时达到顶峰。
35、父母的血型基因型分别为BB和OO,则孩子的血型是
A、A型B、B型
C、AB型
D、O型
E、B型和O型
【答案】B
【解析】父母血型分别为BB(B型)和OO(O型)。
根据血型遗传规律,B型的显性基因(B)可以传递给子代,而O型的隐性基因(O)同样可以传递给子代。
因此,孩子继承的血型基因型可能是BO,即B型。
所以正确答案是B: B型。
36、弗氏不完全佐剂的组成包括
A、液体石蜡、羊毛脂、卡介苗B、液体石蜡、卡介苗
C、液体石蜡、羊毛脂
D、羊毛脂、卡介苗
E、羊毛脂、卡介苗、氢氧化铝
【答案】C
【解析】弗氏不完全佐剂是羊毛脂与液状石蜡的混合物。
37、无论被测物浓度高低,实验室测定结果总是持续偏低,说明有
A、随机误差B、过失误差
C、系统误差
D、偶然误差
E、误差来源无法判断
【答案】C
【解析】答案选C:系统误差。
解析:产生的检验误差有两类,一是系统误差,二是随机误差。待测物的测定值与一可接受参考值之间的差异。偏倚又分批内偏倚和批间偏倚,批内偏倚反映的是该批测定的系统误差,如校准不准、非特异显色等。实验室测定结果总是持续偏低,说明是系统误差。
38、下列不属于免疫分子的是
A、补体B、干扰素
C、免疫球蛋白
D、人类白细胞分化抗原
E、变应原
【答案】E
【解析】变应原不属于免疫分子。
免疫分子包括免疫球蛋白、补体、细胞因子、细胞黏附分子、人类白细胞分化抗原等。
它们在免疫系统中扮演关键角色,参与识别、清除外来物质或自身异常细胞的过程。
39、低钾血症的界值是
A、2.5mmol/LB、3.5mmol/L
C、4.5mmol/L
D、5.5mmol/L
E、6.5mmol/L
【答案】B
【解析】低钾血症的界值是3.5mmol/L。
当血清钾浓度低于这个值时,即认为存在低钾血症。
40、电阻抗法检测白细胞时,白细胞直方图中,中间细胞群的分布范围是
A、35~90flB、90~120fl
C、90~160fl
D、160~180fl
E、180~230fl
【答案】C
【解析】白细胞直方图中,中间细胞群的分布范围是90~160fl,这一区间包含了单核细胞、嗜酸性粒细胞、嗜碱性粒细胞、原始细胞及幼稚细胞等。
41、最常用于区分原始淋巴细胞和原始粒细胞的细胞化学染色是
A、POX染色B、PAS染色
C、ALP染色
D、ACP染色
E、AS-DNAE染色
【答案】A
【解析】POX染色:急性粒细胞白血病时,白血病性原始粒细胞可呈阳性反应,阳性颗粒一般较多,较粗大,常呈局限性分布;急性淋巴细胞白血病时,原始淋巴细胞和幼淋巴细胞均呈阴性反应。
42、体内生物转化作用最强的器官是
A、肾脏B、肝脏
C、心脏
D、胃肠道
E、脾
【答案】B
【解析】体内生物转化作用最强的器官是肝脏。
肝脏负责处理和代谢体内的各种物质,包括内源性代谢产物和外源性的药物、毒素等。
其他器官如肾脏、肺、肠也有一定的生物转化能力,但通常情况下,肝脏是进行生物转化作用最强的器官。
43、能与钙离子形成螯合物,并产生抗凝作用的抗凝剂是
A、肝素钠B、草酸钠
C、草酸钾
D、肝素锂
E、枸橼酸钠
【答案】E
【解析】答案是E: 枸橼酸钠。
它能与钙离子形成螯合物,从而发挥抗凝作用。
44、如图示,尿沉渣涂片所见的细胞为
A、红细胞
B、白细胞
C、移行上皮细胞
D、鳞状上皮细胞
E、肾小管上皮细胞
【答案】A
【解析】尿中未经染色的红细胞形状为双凹圆盘状,浅黄色,直径大约8μm。
45、如图所示,箭头所指的细胞

A、杆状核中性粒细胞
B、分叶核中性粒细胞
C、巨多分叶核中性粒细胞
D、嗜碱性粒细胞
E、嗜酸性粒细胞
【答案】B
【解析】中性分叶核粒细胞,胞体直径10~14μm,圆形。胞核分叶状,常分2~5叶,核染色质浓集或呈较多小块。胞质丰富,浆内分布着细小紫红色中性颗粒。
46、关于钠离子和钾离子的叙述,正确的是
A、钾离子主要存在于细胞外液B、钠离子主要存在于细胞内液
C、钾为细胞外液的主要阳离子
D、钠为细胞内液的主要阳离子
E、钠、钾细胞内外的转运需要消耗能量
【答案】E
【解析】细胞内外液中钠和钾的浓度有如此巨大差别,主要由于细胞膜上的特殊结构即Na+-K+ATP酶(钠泵)的作用,钠泵可主动将细胞内液的钠离子运转到细胞外液,而将钾离子转移到细胞内液,这个过程是一个耗能的过程。故选E。
47、医技科室可以将患者的检查检验结果报告给谁
A、检查检验的申请者B、不负责该患者的临床医生
C、未经患者同意的其他人员
D、依据法律不可知悉的人员
E、认识该患者的其他人员
【答案】A
【解析】医技科室应将患者的检查检验结果直接报告给检查检验的申请者。
这确保了医疗信息的准确传递,符合医疗流程和患者隐私保护原则。
未经正当程序,医技科室不得向非申请者泄露或报告患者检查检验结果。
48、正常情况下,不能通过肾小球滤过膜的物质是
A、血细胞B、肌酸
C、尿酸
D、肌酐
E、尿素
【答案】A
【解析】正常情况下,不能通过肾小球滤过膜的物质是血细胞。
当机体的循环血液流经肾小球时,由于肾小球滤过膜的屏障作用,血液中的细胞成分及大部分血浆蛋白无法通过,而其余成分几乎全部被滤入肾小囊腔内,形成肾小球滤过液,称为原尿。
49、患儿男,3岁。脑膜刺激征阳性,腰穿脑脊液呈云雾状,拟诊断为细菌性脑膜炎,脑脊液培养阳性,细菌鉴定:卫星试验(+),该致病菌最可能是
A、流感嗜血杆菌B、脑膜炎奈瑟菌
C、金黄色葡萄球菌
D、B群链球菌
E、肺炎球菌
【答案】A
【解析】流感嗜血杆菌与金黄色葡萄球菌共培养时会出现卫星现象,即流感嗜血杆菌菌落围绕葡萄球菌菌落生长,大小不一,形成卫星状分布。
这一现象是由于葡萄球菌能提供流感嗜血杆菌生长所需的Ⅴ因子。
因此,当观察到脑脊液培养阳性样本中存在这种卫星现象时,可以推断致病菌为流感嗜血杆菌。
50、FITC在紫外光激发下,所产生的荧光为
A、灰蓝色B、黄绿色
C、橙色
D、橙红色
E、黄色
【答案】B
【解析】FITC在紫外光激发下产生的荧光颜色是黄绿色。
51、血液中具有抵抗外界异物入侵功能的是
A、血小板B、红细胞
C、白细胞
D、单核细胞
E、淋巴细胞
【答案】C
【解析】白细胞(WBC)是外周血常见的有核细胞,根据形态特征,可分为粒细胞(GRA)、淋巴细胞(L)和单核细胞(M)3类。粒细胞在组织中可行使防御功能1~2d,衰老的粒细胞主要在单核吞噬细胞系统破坏,其余从口腔、气管、消化道、泌尿生殖道排出,同时,骨髓释放新生的粒细胞补充外周血而保持白细胞数量相对恒定。
白细胞通过多种机制如吞噬作用和产生抗微生物物质来保护机体免受感染和其他外来威胁。
因此,正确答案是 C: 白细胞。
52、关于肝脏在血糖调节中的作用,下列哪一说法错误
A、糖异生B、合成糖原
C、糖的氧化
D、肝糖原分解
E、葡萄糖转化为其他单糖
【答案】E
【解析】关于肝脏在血糖调节中的作用,错误的说法是葡萄糖转化为其他单糖(选项E)。
肝脏主要通过糖异生、合成糖原、糖的氧化以及肝糖原分解等过程来调节血糖水平,但不直接将葡萄糖转化为其他单糖作为主要功能。
53、患者,男,38岁。发热,意识障碍,体征表现为颈项强直,布氏征、克氏征阳性,脑脊液压力增高,直接涂片墨汁染色见大而圆的菌体,有一厚壁,可疑为
A、流行性脑脊髓膜炎B、新型隐球菌性脑膜炎
C、流感嗜血杆菌脑膜炎
D、结核性脑膜炎
E、葡萄球菌脑膜炎
【答案】B
【解析】新型隐球菌为圆形的酵母型菌,外周有荚膜,折光性强。一般染色法不着色,难以发现。用印度墨汁作负染色镜检,在黑色的背景中可见圆形的透明菌体,为双壁细胞,外包有一层透明的荚膜,故选B。
54、抗酸染色呈红色的细菌是
A、支气管败血波氏菌B、结核分枝杆菌
C、鸭疫里氏杆菌
D、产单核细胞李斯特菌
E、鼻疽伯氏菌
【答案】B
【解析】抗酸染色呈红色的细菌是结核分枝杆菌(选项B)。
这类细菌因其体内富含脂类物质,导致在抗酸染色过程中不易被着色剂染色,即便经过碘液处理,也不易被盐酸乙醇脱色,最终呈现出红色。
55、尿沉渣镜检涂片如图所示,箭头所示的细胞是
A、红细胞
B、白细胞
C、上皮细胞
D、吞噬细胞
E、卵磷脂小体
【答案】C
【解析】大圆上皮细胞:为表层移行上皮细胞,胞体较大,如果在器官充盈时脱落,则胞体较大,为白细胞的4~5倍,多呈不规则圆形,核较小,常居中。如在器官收缩时脱落,则胞体较小,为白细胞的2~3倍,形态较圆。
56、抗原抗体反应的特点不包括
A、特异性B、交叉牲
C、可逆性
D、比例性
E、阶段性
【答案】B
【解析】抗原抗体反应的特点不包括“交叉性”。
抗原抗体反应的特点:特异性、可逆性、比例性、阶段性。
57、用肉眼即可判定抗原、抗体反应结果的试验是
A、间接荧光免疫技术B、凝集反应
C、化学反应技术
D、放射免疫技术
E、电化学发光免疫技术
【答案】B
【解析】凝集试验是一个定性的检测方法,即根据凝集现象的出现与否判定结果阴性或阳性;也可以进行半定量检测。
(58~60为共用题干)
患者,女,25岁。2年来反复双下肢紫癜、鼻出血、牙龈出血,病前无服药史。体检:一般情况好,脾侧卧位肋下15cm,双下肢散在紫癜,余无明显异常。实验室检查血红蛋白:95g/L,白细胞:5.0×109/L,血小板:35×109/L,血沉15mm/h,束臂试验(+)。
58、本病目前最可能的诊断是
A、特发性血小板减少性紫癜B、血小板第3因子缺乏症
C、血小板无力症
D、血管性紫癜
E、血友病
【答案】A
【解析】免疫性血小板减少症(ITP)又称特发性血小板减少性紫癜,是一种自身免疫性疾病,慢性型多数见于青壮年,以女性为多见。常无诱发因素,起病缓慢,出血以皮肤、黏膜和月经量过多为主,脾不大或稍大,病程长至1~数年,且有反复发作的倾向。实验室检查:多次血小板计数明显减低。该患者女,25岁。2年来反复双下肢紫癜、鼻出血、牙龈出血,病前无服药史。体检:一般情况好,脾侧卧位肋下15cm,双下肢散在紫癜,余无明显异常。实验室检查血小板:35×109/L,束臂试验(+)。目前最可能的诊断是特发性血小板减少性紫癜。
59、为明确诊断,没有必要做的检查是
A、骨髓穿刺检查B、PT测定
C、血小板寿命测定
D、血块收缩试验
E、血小板相关免疫球蛋白检测
【答案】B
【解析】束臂试验为血小板的量和/或质异常,如原发性和继发性血小板减少症、血小板增多症、先天性(遗传性)和获得性血小板功能缺陷症;属于一期止血缺陷筛查试验,而PT测定为二期止血缺陷筛查试验,故没有必要做。
60、如果确诊为该病,说法错误的是
A、临床上可分为急性型和慢性型,后者主要见于成年女性;前者主要见于儿童B、是一种自身免疫性疾病
C、主要由于骨髓巨核细胞生成障碍而引起
D、慢性型患者病情常反复发作
E、急性型主要见于儿童
【答案】C
【解析】免疫性血小板减少性紫癜(ITP)是一种常见的血小板减少症,主要表现为皮肤黏膜紫癜,血小板减少,骨髓中巨核细胞正常或增多。
(61~63为共用备选答案)
A、CRHB、GHRH
C、TRH
D、GnRH
E、PRH
61、调节生长激素分泌的是
【答案】B【解析】调节生长激素分泌的主要激素是生长激素释放激素(GHRH)。
当体内GHRH水平升高时,会促进垂体释放生长激素;
相反,生长激素抑制激素(Somatostatin)则会抑制生长激素的分泌。
因此,正确答案是B: GHRH。
62、促进肾上腺皮质激素分泌的是
【答案】A【解析】解析:促进肾上腺皮质激素分泌的主要是CRH(促肾上腺皮质激素释放素)。
当下丘脑释放CRH时,它会刺激垂体分泌ACTH(促肾上腺皮质激素),进而促使肾上腺皮质释放皮质激素。
63、促进促甲状腺激素分泌的是
【答案】C【解析】解析:促甲状腺激素(TSH)的分泌受到血液中游离T3、T4水平的调控。
当这些激素水平下降时,会通过负反馈机制刺激下丘脑释放促甲状腺激素释放激素(TRH),进而促进垂体分泌TSH,以增加甲状腺激素的合成与释放。
因此,促进促甲状腺激素分泌的直接调节因子是TRH。
(64~65为共用备选答案)
A、MCV正常、RDW正常B、MCV正常、RDW异常
C、MCV增高、RDW异常
D、MCV降低、RDW正常
E、MCV降低、RDW异常
64、红细胞呈正常细胞不均一性时
【答案】B【解析】正常细胞不均一性贫血表现为红细胞体积大小基本一致(MCV正常),但红细胞的体积分布宽度(RDW)异常升高。
这是因为虽然红细胞平均体积没有显著变化,但细胞间体积存在较大差异,导致RDW值增大。
因此,正确答案是B:MCV正常、RDW异常。
65、红细胞呈小细胞不均一性时
【答案】E【解析】小细胞不均一性贫血的特点是红细胞大小不一致,且平均体积减小。
因此,其MCV(平均红细胞体积)值会低于正常范围,而RDW(红细胞体积分布宽度)则会异常升高,反映红细胞体积的显著变异。
所以正确答案是E:MCV降低、RDW异常。
(66~67为共用备选答案)
A、中幼红细胞B、浆细胞
C、淋巴细胞
D、原始粒细胞
E、原始单核细胞
66、胞质有浑浊泡沫感,核偏位。可见核旁淡染区,染色质呈车轮状的细胞是
【答案】B【解析】浆细胞:胞体直径8~15μm,圆或椭圆形。胞核明显缩小,较圆可占细胞的1/3以下,偏于细胞一侧,核染色质浓密成块,常排列成车轮状,无核仁。胞质丰富,染蓝色或红蓝相混的蓝紫色,有泡沫感,核的外侧常有明显的淡染区,浆内常有小空泡,偶见少数颗粒。
67、核圆形居中,染色质呈沙粒状,分布均匀核仁2~5个,小而清新,胞质天蓝色的细胞是
【答案】D【解析】原始粒细胞:胞体直径10~20μm,圆形或类椭圆形。胞核较大,约占细胞的2/3以上,核染色质呈细粒状,排列均匀,无浓集,核膜较模糊。核仁2~5个,较小,清楚。胞质量少,呈透明天蓝色,绕于核周,无颗粒。
(68~70为共用备选答案)
A、肾小球B、近曲小管
C、髓袢
D、远曲小管
E、集合管
68、具有“逆流倍增”的功能,在尿液浓缩稀释功能中起重要作用的是
【答案】C【解析】在尿液浓缩稀释过程中,髓袢发挥关键作用,具备“逆流倍增”功能,主要吸收水和氯化钠,从而对尿液的浓度进行调节。
因此,正确答案是C:髓袢。
69、具有选择性滤过功能的是
【答案】A【解析】选择性滤过功能主要由肾小球滤过膜承担,其允许小分子物质透过而阻止大分子如血细胞和蛋白质,从而维持体内环境稳定。
因此,具有选择性滤过功能的关键结构是A:肾小球。
70、肾重吸收最重要的部位是
【答案】B【解析】肾重吸收最重要的部位是近曲小管。
这是因为在这个区域,大量的营养物质如葡萄糖、小分子蛋白质以及大部分水分被重吸收回血液,是物质回收的关键环节。
(71~72为共用备选答案)
A、白纹伊蚊B、埃及斑蚊
C、淡色库蚊
D、中华按蚊
E、亚洲虎蚊
71、在我国马来丝虫的主要传播媒介是
【答案】D【解析】在中国,马来丝虫的主要传播媒介是中华按蚊。
马来丝虫通过蚊子叮咬进行传播,其中中华按蚊因其在特定地区的生活习性和活动模式,成为这种疾病的主要传播媒介。
其他选项如白纹伊蚊、埃及斑蚊、淡色库蚊和亚洲虎蚊虽然也是蚊类,但在传播马来丝虫方面并不作为主要媒介。
因此,在我国控制马来丝虫疾病时,针对中华按蚊的防治措施尤为重要。
72、在我国班氏丝虫的主要传播媒介是
【答案】C【解析】在中国,班氏丝虫病的主要传播媒介是淡色库蚊。
(73~74为共用备选答案)
A、HbAB、HbF
C、HbS
D、HbCO
E、HiCN
73、抗碱血红蛋白的简写是
【答案】B【解析】抗碱血红蛋白指的是HbF,它是胎儿时期的主要血红蛋白类型,具有较强的抗碱性。
74、氰化高铁血红蛋白简写是
【答案】E【解析】氰化高铁血红蛋白简写为HiCN。
(75~76为共用题干)
患儿男,发热1周,咽痛,免疫接种史不详。查体:咽后壁、腭弓等处可见灰白色膜状物,涂片显示革兰氏阳性棒状杆菌,并有明显异染颗粒。
75、可能的诊断是
A、肺炎克雷伯菌B、大肠埃希菌
C、白喉棒状杆菌
D、变形杆菌
E、伤寒沙门菌
【答案】C
【解析】白喉棒状杆菌具有在细菌一端或两端有浓染的异染颗粒这一形态学特征。
使用亚甲蓝、Neisser(奈瑟)或Albert(阿培特)染色法时,可观察到菌体与颗粒之间的颜色差异,其中异染颗粒呈现蓝黑色或紫黑色。
这一特点对于识别白喉棒状杆菌具有重要意义。
因此,在临床中,当发现疑似白喉棒状杆菌的病原体时,可以通过观察其特有的异染颗粒来确诊。
76、最后确定感染的细菌为白喉棒状杆菌,其所致疾病为
A、细菌性肺炎B、流行性腮腺炎
C、白喉
D、腺病毒性肺炎
E、结核
【答案】C
【解析】白喉是由白喉棒状杆菌引起的一种急性呼吸道传染病,主要症状包括咽喉部出现灰白色假膜,伴有剧烈咳嗽和呼吸困难。
此病多在秋冬季节流行,咽白喉最为常见,可累及喉部、鼻腔、眼部结膜、外耳道、阴道以及皮肤等部位。
因此,当患者出现上述临床表现时,最终确定的感染细菌为白喉棒状杆菌,所导致的疾病即为白喉。
(77~80为共用题干)
患者女,32岁。在一次体检时发现RBC2.8×1012/L,Hb92g/L,MCV110fl,MCH34pg,MCHC330g/L。
77、该患者最可能的诊断是
A、再生障碍性贫血B、缺铁性贫血
C、铁粒幼细胞贫血
D、巨幼红细胞性贫血
E、溶血性贫血
【答案】D
【解析】精简重要解析:
- 患者红细胞参数异常,表现为MCV升高(110fl),排除缺铁性贫血和铁粒幼细胞贫血;
- MCH和MCHC正常,排除溶血性贫血;
-
因此,最可能的诊断是巨幼红细胞性贫血,这是由于维生素B12或叶酸缺乏导致的红细胞体积增大但其他参数正常的贫血类型。
78、还需要进一步做的检查是
A、ESRB、血清总结合力
C、血涂片
D、RET
E、PLT
【答案】C
【解析】血涂片观察一方面用于估计血细胞的相对数量,作为仪器质控的方法之一,另一方面通过形态学识别,初步判断贫血原因。但制片不当也常使细胞鉴别发生困难,甚至产生错误结论。
79、该患者最可能的临床诊断是
A、再生障碍性贫血B、缺铁性贫血
C、铁幼粒细胞贫血
D、巨幼细胞贫血
E、溶血性贫血
【答案】D
【解析】巨幼细胞贫血骨髓象,主要表现三系细胞巨幼样变,尤其是红细胞系列出现早、中和晚巨幼红细胞>10%,粒细胞和巨核细胞系统亦有巨幼样变。
因此,根据红细胞形态学异常的特点,最可能的临床诊断是E:巨血小板综合征。
80、为明确诊断,首选的试验是
A、血小板聚集试验B、骨髓细胞学检查
C、血浆FⅧ:C测定
D、血浆vWF:Ag测定
E、狼疮抗凝物质
【答案】B
【解析】巨幼细胞性贫血骨髓象,主要表现三系细胞巨幼样变,尤其是红细胞系列出现早、中、晚巨幼红细胞常>10%,粒细胞和巨核细胞系统亦有巨幼样变。
(81~83为共用题干)
某大学食堂在一次午餐后,部分同学出现呕吐、腹泻等消化道症状。对呕吐物进行细菌培养,血平板上出现O溶血,并产生金黄色菌落。
81、此菌最可能是
A、金黄色葡萄球菌B、草绿色链球菌
C、奈瑟菌
D、大肠埃希菌
E、痢疾志贺菌
【答案】A
【解析】葡萄球菌属的培养特性:在血琼脂平板上,葡萄球菌可产生α、β、γ和δ溶血素,可产生不同的脂溶性色素,如金黄色、白色、柠檬色色素。金黄色葡萄球菌产生的肠毒素可引起食物中毒,表现为急性胃肠炎。故结合题干,符合金黄色葡萄球菌感染的诊断。
82、可判断检出菌是否具有致病性的试验是
A、触酶试验B、血浆凝固酶试验
C、丙二酸试验
D、氧化酶实验
E、O/F实验
【答案】B
【解析】血浆凝固酶是金黄色葡萄球菌所产生的一种与其致病力有关的侵袭性酶,分游离型和结合型两种。因此血浆凝固酶试验可判断检出菌是否具有致病性。
83、在食堂厨师手上发现了化脓性伤口,并有脓液渗出,在做细菌培养时需接种的培养基为
A、血平板B、巧克力平板
C、高盐甘露醇平板
D、MAC平板
E、SS平板
【答案】A
【解析】金黄色葡萄球菌的分离培养:脓汁、尿道分泌物、脑脊液离心沉淀物,通常可直接接种血琼脂平板。故选A。
(84~86为共用题干)
患者,女,23岁。低热、头痛、乏力、腹痛,水样便。近日旅游时生食海鲜、生鱼片等食物。大便镜检见大量运动活跃的弧状杆菌。
84、该患者感染的致病菌是
A、大肠埃希菌B、副溶血性弧菌
C、奇异变形杆菌
D、肠炎沙门菌
E、霍乱弧菌
【答案】B
【解析】患者出现的症状(低热、头痛乏力、腹痛、水样便)以及检查发现大量运动活跃的弧状杆菌,结合旅行期间食用过海鲜、生鱼片等食物的历史,提示可能存在食物中毒的情况。
根据这些线索,正确的致病菌是副溶血性弧菌。
这种细菌常见于近海海水、海产品及盐渍食品中,且具有嗜盐性,能够引起食物中毒症状。
因此,本题答案选B:副溶血性弧菌。
85、合适的分离培养基是
A、血琼脂培养基B、EMB培养基
C、SS培养基
D、TCBS培养基
E、Skirrow培养基
【答案】D
【解析】解析如下:
- 问题场景:患者有低热、头痛乏力、腹痛、水样便症状,并且近期旅游期间食用过海鲜、生鱼片等食物。
- 检查结果:大便镜检发现大量运动活跃的弧状杆菌。
- 目标:选择合适的分离培养基进行细菌培养。
- 解析关键点:
- 细菌特征:运动活跃的弧状杆菌,提示可能为弧菌属细菌。
- 症状关联:与弧菌属细菌感染的症状(如腹泻)相符合。
- 分离培养基选择依据:TCBS培养基专门用于分离培养副溶血性弧菌,该细菌在TCBS琼脂上生长良好且具有特定的颜色反应(蓝绿色),这使得它易于与其他细菌区分开来。
- 结论:基于上述分析,合适的分离培养基是D选项:TCBS培养基。
86、可判断该致病菌是否有致病性的试验是
A、肥达试验B、神奈川试验
C、锡克试验
D、Elek试验
E、外斐试验
【答案】B
【解析】判断副溶血性弧菌致病性的试验是神奈川试验。
此试验通过观察细菌对不同种类红细胞的溶血作用来判断细菌的致病性。
如果细菌对人或兔红细胞具有溶血作用,但对马红细胞无此作用,则试验结果为阳性,表明存在致病性副溶血性弧菌。
(87~88为共用备选答案)
A、平衡离心法B、差速离心法
C、速率区带离心法
D、等密度区带离心法
E、分析性超速离心法
87、用于分离样品中粒子大小差异大而密度相同的物质,首选的离心法是
【答案】C【解析】速率区带离心法适用于分离粒子大小不同但密度相同的物质。
通过离心,样品中的不同大小粒子形成不同的区带,从而实现分离。
因此,当需要处理这类样品时,选择速率区带离心法则更为合适。
88、用于分离样品中粒子大小相似而密度差异较大的物质,首选的离心法是
【答案】D【解析】等密度区带离心法适用于分离大小相似但密度有差异的物质。
在该方法中,如果粒子密度小于管底介质的密度,粒子会上浮至介质顶部形成清晰的区带。
因此,选择等密度区带离心法是针对具有类似大小但不同密度的样品进行有效分离的最佳方法。
(89~90为共用备选答案)
A、低密度脂蛋白B、高密度脂蛋白
C、中间密度脂蛋白
D、极低密度脂蛋白
E、乳糜微粒
89、LDL是
【答案】A【解析】超速离心法则是根据脂蛋白在一定密度的介质中进行离心时,漂浮速率不同进行分类,可分为乳糜微粒、极低密度脂蛋白(VLDL)、中间密度脂蛋白(IDL)、低密度脂蛋白(LDL)和高密度脂蛋白(HDL)。因此,了解LDL及其在血脂谱中的位置对于评估个体的心血管健康状况至关重要。
90、ApoAⅠ主要在
【答案】B【解析】ApoAⅠ主要存在于高密度脂蛋白(HDL)中。
(91~93为共用题干)
患者,男,65岁。背部疼痛半年有余,时有不规则发热,伴尿频、尿痛就诊。实验室检查:尿蛋白(+++),白细胞10~15/HP,尿本-周蛋白阳性,血清蛋白电泳在β和γ区之间有一M蛋白39.5%,拟诊为多发性骨髓瘤。
91、下列哪项实验室检查最有助于确定本病例的诊断
A、肾功能损害B、血黏度升高
C、免疫球蛋白测定有单株Ig升高
D、骨髓X线摄片有多处骨质破坏
E、骨髓象示异常浆细胞超过15%
【答案】E
【解析】本题答案选E:骨髓象示异常浆细胞超过15%。
解析要点:
- 多发性骨髓瘤的诊断关键在于骨髓象检查,显示异常浆细胞超过15%。
- 此指标直接反映了骨髓中异常浆细胞的比例,是诊断的重要依据。
- 其他选项虽与病情相关,但不直接指向诊断的关键点。
因此,选择E选项最能准确反映题目的核心要求。
92、此例M蛋白最不可能是
A、IgGB、IgA
C、IgM
D、轻链
E、IgG+轻链
【答案】C
【解析】精简重要解析:
多发性骨髓瘤患者的M蛋白主要为IgG、IgA、轻链型,而极少表现为IgM型。
因此,本题答案为C:IgM。
93、假如在病程后期患者高热、咳嗽、两肺有湿啰音,外周血片浆细胞占23%,浆细胞绝对计数2.2×109/L,此时诊断是
A、肺炎B、浆细胞性类白血病
C、浆细胞性白血病
D、反应性浆细胞增多症
E、终末期多发性骨髓瘤
【答案】C
【解析】在病程后期,患者出现高热、咳嗽及两肺湿啰音,并且外周血片中浆细胞比例显著增加至23%,同时浆细胞绝对计数达到2.2×109/L,这表明了浆细胞数量的异常增多,已超出多发性骨髓瘤的标准范围。
结合浆细胞的比例和绝对计数,可以判断患者处于浆细胞白血病的状态。
浆细胞白血病是指血液中浆细胞比例超过20%,或者浆细胞的绝对计数超过2×109/L的情况。
因此,正确的答案是C: 浆细胞性白血病。

